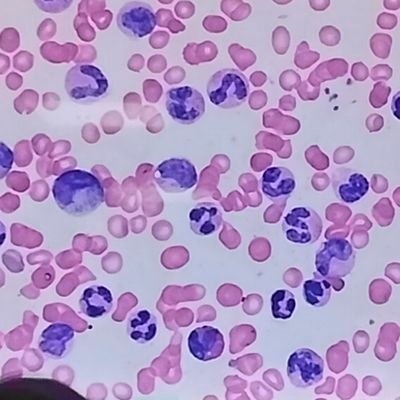
JRMT497590's profile picture. RMT by March 11, 2026 🫶

TOPNOTCHER !!

joy, RMT, MLS (ASCPi)
@mjlbnotes
2024 RMT, MLS (ASCPi), DTA | Ask questions: https://zaqa.net/mjlbnotes
You might like
If anyone of you wants FREE Medtech Notes & Anki Decks, join my tg channel below🔬🤍 I have uploaded book summaries (Strasinger, Stevens, Zeibig) & updated my Anki Decks folder (CM Pictures, AABB & DOH Deferrals, Nobel Prizes, Histopath Fixation) 💫 t.me/MJLBNotes


4 Main Types of Hypersensitivity Reactions: ACID Type I: Anaphylactic / Allergic Type II: Cytotoxic Type III: Immune Complex Type IV: Delayed
thread on how i ring bound my review materials (fr lemar) ⊹˚. ♡.𖥔 ref vid: vt.tiktok.com/ZSFKSy8sG/


if you're a march 2026 MTLE reviewee or a medtech student, feel free to follow my TG channel. i post free flashcards, medtech materials & study tips on there! good luck fRMTs 🫶 t.me/MJLBNotes
pag nag ka time ako i’ll try to upload more free anki decks ng mga prac qs for MTLE! good luck sa mga reviewees ngayon ✨
recos for 11.11 ✨ i’ll try to make an updated version of this thread!!!
hello RMTs, since you’ll be entering your working gorl era soon, here are some of my scrub suit recos/review + other options u can buy online — a thread🔬🌟

I made a CM Anki Deck consisting of a compilation of pictures from Strasinger 🔬✨ if you’re interested, just join my TG channel - I posted the link there! Free lang to btw so pls don’t sell it hehe t.me/MJLBNotes
What to do next after passing the boards (MTLE)🔬🪪 — a thread • Oath Taking • Initial Registration • Claiming Certificates Get a PDF copy of the thread + FREE medtech notes here: t.me/MJLBNotes
hello RMTs, since you’ll be entering your working gorl era soon, here are some of my scrub suit recos/review + other options u can buy online — a thread🔬🌟

Here are some must-read MedTech books that will guide you through your undergrad years and help you ace your MTLE review! 🔬✨ Good luck, fRMTs!!! vt.tiktok.com/ZSU87D7Cg/ Get free PDF copies here: t.me/MJLBNotes
let me know if may qs kayo regarding the DTA workshop or anything MT related, i'll make a thread/vid soon! you can ask here if ever hehe zaqa.net/mjlbnotes
para sa mga bagong RMTs this aug 2025, hope this helps!!! congrats again 🥳🔬✨
What to do next after passing the boards (MTLE)🔬🪪 — a thread • Oath Taking • Initial Registration • Claiming Certificates Get a PDF copy of the thread + FREE medtech notes here: t.me/MJLBNotes




congrats RMTs!!!!!! iready na ang oathtaking fits 🥳🫶🏻
congrats na agad fRMTs!!!! you did well 🌟🌟RMT NA YAN NEXT WEEK
Hematology Must-Know: Cell Cycle Phase🩸(MEMORIZE!)

lapit na dta training ko aaahh, buti nalang nakahabol ako sa slots 😩✨ will post a thread pag natapos ko n sya!
Blood Banking Must-Know: Antibodies & sources of neutralizing substance 🩸🆎 (RECALL)

United States Trends
- 1. #DWTS 36.6K posts
- 2. Alix 10.3K posts
- 3. Robert 98.5K posts
- 4. Elaine 34.5K posts
- 5. Carrie Ann 3,429 posts
- 6. Anthony Black 2,223 posts
- 7. Dylan 31.4K posts
- 8. Drummond 2,314 posts
- 9. #WWENXT 6,764 posts
- 10. Suggs 2,241 posts
- 11. Jalen Johnson 3,725 posts
- 12. Ezra 10.8K posts
- 13. Daniella 2,578 posts
- 14. #DancingWithTheStars 1,102 posts
- 15. Godzilla 31.4K posts
- 16. Wizards 8,741 posts
- 17. CJ McCollum 1,511 posts
- 18. Bruce Pearl N/A
- 19. #NXTGoldRush 5,433 posts
- 20. Brown 154K posts
Something went wrong.
Something went wrong.